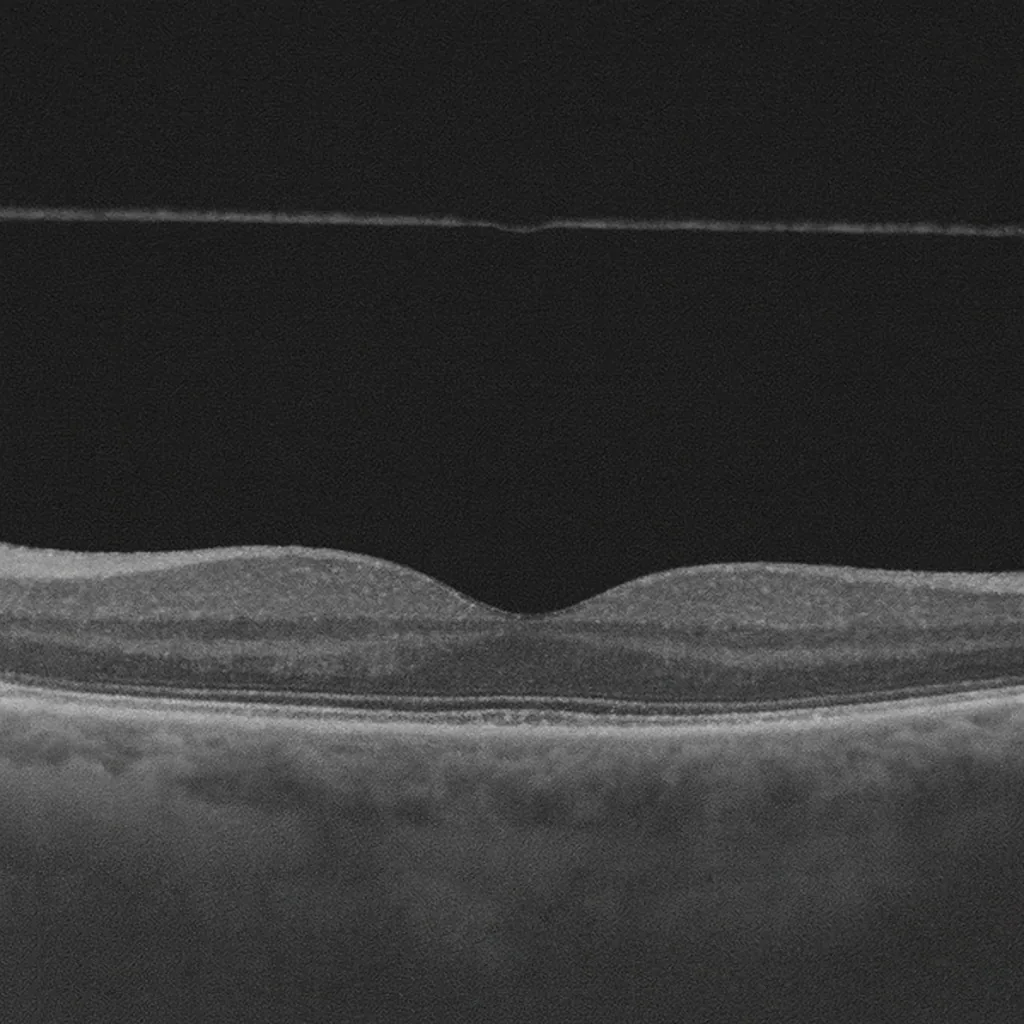
Décollement postérieur du vitré - examen fond d'œil

Posterior vitreous detachment (PVD) occurs when the vitreous gel separates from the retina. Common after age 50 and often benign — but it is complicated by a retinal tear in 10 to 15% of cases.
Why an urgent examination is essential
A simple PVD cannot be distinguished from a complicated one (with tear) without a dilated fundus examination. In case of sudden onset of floaters or flashes of light, do not postpone the consultation until the next day.
Further reading
Read the complete article by Dr Julien Gozlan : Posterior vitreous detachment — complete explanation
Do you have these symptoms?
Dr Julien Gozlan will respond within minutes.